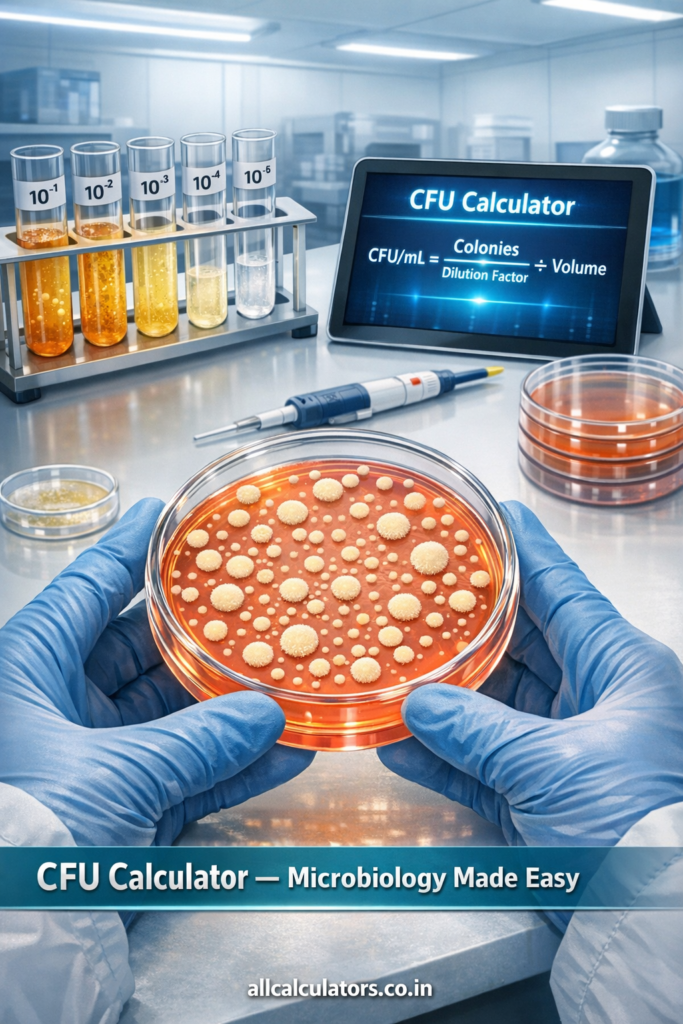

🧫 Colony Forming Unit Calculator
🌿 Ecology · Population & Environmental Biology& Total CFU = CFU/mL × Total Sample Volume (mL)
📖 What is CFU? – Quick Guide
- 🔬 Used in water quality testing, food safety, pharmaceutical QC, and environmental monitoring.
- 🌿 Key parameter in ecology and population biology studies of microbial communities.
- 🏥 Clinically relevant for infection load assessment and antibiotic efficacy.
🔬 How to Use This Calculator
- Colonies Counted: Count visible colonies on your agar plate (TNTC = too numerous, TFTC = too few; ideal range 30–300).
- Volume Plated: The volume of diluted suspension you spread or poured (typically 0.1 mL for spread plates, 1.0 mL for pour plates).
- Number of Dilutions: How many serial dilution steps were performed (e.g., 10-5 = 5 steps at 1:10).
- Dilution Ratio: The factor per step (most commonly 1:10).
- Total Sample Volume: Volume of your original undiluted sample, used to compute total organism count.
Table of Contents
✍️ Author & Academic Authority: Dr. Nitish Kr. Bharadwaj
📘 Qualifications: B.Sc., B.Ed., M.Sc., Ph.D. (Biochemistry), MBA (Financial Management)
🧫 Colony Forming Unit Calculator
Instantly Calculate Bacterial & Fungal Cell Concentration Online
🔬 What is a Colony Forming Unit ? In the fascinating world of microbiology and immunology, understanding the number of living, viable microorganisms in a given sample is one of the most foundational and critical skills a scientist, student, or lab technician must master. A Colony Forming Unit (CFU) is a scientific measurement unit used to quantify the number of viable — meaning alive and capable of reproducing — bacterial or fungal cells present in a sample. Unlike total cell counts that include both dead and living cells (such as those obtained through direct microscopic counting using a hemocytometer), the CFU method counts only those cells that are metabolically active and capable of forming visible colonies on a nutrient-rich agar plate. This makes CFU one of the most accurate and widely trusted measures of live microbial concentration in biology, food science, clinical microbiology, pharmaceutical testing, and environmental monitoring.

🧪 The Science Behind Colony Forming Unit Calculation
The principle behind calculating Colony Forming Units is elegantly simple yet powerfully informative. When a liquid sample containing bacteria or fungi is spread onto or poured into a solid agar plate and incubated under ideal conditions of temperature, humidity, and time, each viable cell — or tightly clustered group of cells — divides and multiplies into a visible colony. This colony is counted as one CFU, because it originated from a single colony-forming event. The universally accepted formula for calculating CFU concentration is:
📐 CFU Formula: CFU/mL = (Number of Colonies × Dilution Factor) ÷ Volume Plated (in mL)
Or for solid samples: CFU/g = (Number of Colonies × Dilution Factor) ÷ Weight of Sample (in grams)
For example, if a microbiologist counts 130 colonies on an agar plate prepared from a 10⁻⁶ dilution using a plating volume of 1 mL, the original bacterial concentration is calculated as: CFU/mL = 130 × 10⁶ ÷ 1 = 1.3 × 10⁸ CFU/mL (or 130,000,000 viable cells per milliliter).
This number tells the scientist how densely populated the original sample was with living bacteria — a piece of information that can be life-saving in clinical diagnostics, quality control, and infection control settings.
🔄 Why Serial Dilution is the Key Step?
Because microbial cultures are often extremely dense (reaching billions of cells per mL), directly plating the original sample would result in a plate so crowded with colonies that counting becomes impossible — a condition microbiologists call TNTC (Too Numerous To Count). This is why serial dilution — the process of systematically diluting the sample in steps, typically 10-fold (1:10) each time — is performed before plating. Standard practice recommends choosing a plate with 30 to 300 colonies for reliable and statistically valid results. Plates with fewer than 30 colonies may not be representative of the true population (undercounting risk), while plates with more than 300 colonies may cause merged or overlapping colonies (overcounting risk). The dilution factor used for each plate is then plugged into the CFU formula to back-calculate the concentration in the original, undiluted sample.
🧬 CFU vs. Total Cell Count — What’s the Difference? — This distinction is crucial for biology students and researchers. A total cell count using methods like hemocytometry counts every cell — alive or dead — in the field of view. By contrast, CFU measurement exclusively counts metabolically active, colony-forming cells. This makes CFU the gold standard when assessing the safety of a food product, the potency of a probiotic supplement, the sterility of a pharmaceutical batch, or the severity of a bacterial infection in a patient’s urine or blood sample.
📊 Understanding CFU/mL in Log Values — Because CFU values often run into the hundreds of millions or even billions, it is common scientific practice to express results in log₁₀ (logarithmic base 10) form for easier handling and comparison. For example, 1.3 × 10⁸ CFU/mL expressed in log form is simply log₁₀(1.3 × 10⁸) ≈ 8.11 log CFU/mL. Log reduction values are especially important in disinfection and sterilization validation, where regulatory standards (such as those set by the EPA, FDA, and WHO) require demonstrating specific log reductions in microbial populations (e.g., a 5-log reduction means the bacterial count has been reduced by a factor of 100,000).
🏥 Clinical Significance of CFU Thresholds — Clinically, CFU thresholds carry enormous diagnostic weight. For instance:
- A urine sample with ≥10⁵ CFU/mL (100,000 CFU/mL) is the standard threshold for diagnosing a Urinary Tract Infection (UTI).
- Blood culture results showing any growth (even low CFU) are considered clinically significant and indicate bacteremia.
- In cerebrospinal fluid (CSF) samples, >1 CFU/mL is flagged as critical.
- Pharmaceutical sterility testing mandates zero CFU in injectable products.
🛡️ Plating Methods — Pour Plate vs. Spread Plate — Two primary methods are used to plate samples for CFU counting. In the Pour Plate Method, a measured volume of diluted sample (~1 mL) is placed in an empty sterile Petri dish, then molten agar (cooled to ~45°C) is poured in, mixed, and allowed to solidify — trapping bacteria both within and on the surface of the agar. In the Spread Plate Method, a smaller volume (typically 0.1 mL) of diluted sample is pipetted onto an already-solidified agar surface and then spread evenly using a sterile L-shaped spreader or glass beads. The spread plate method is widely used in academic labs and clinical diagnostics due to its simplicity and the clarity of colony counting it allows.

🧫 How CFU Calculation Works in Practice
In a typical experiment, a microbial sample undergoes serial dilution to reduce concentration. A small volume (e.g., 0.1 mL) is then plated onto agar and incubated. After incubation, colonies are counted manually or using digital tools.
However, due to dilution, the observed colonies represent only a fraction of the original sample. The CFU formula corrects this by incorporating:
- 🔢 Number of colonies counted
- 🧪 Dilution factor (e.g., 10⁻⁶)
- 💧 Volume plated
By inputting these values into a bacterial count calculator, you obtain an accurate microbial concentration.
🧠 Importance in Microbiology & Immunology
The CFU calculation is critical across multiple biological disciplines:
- 🦠 Microbiology: Measuring bacterial growth and viability
- 🧬 Immunology: Evaluating immune responses against pathogens
- 🍔 Food Microbiology: Detecting contamination levels
- 💊 Pharmaceuticals: Ensuring sterile drug production
- 🌱 Environmental Science: Monitoring water and soil quality
Accurate CFU measurement directly impacts research validity, product safety, and regulatory compliance.
🌍 Applications in Daily Life
The colony forming unit calculator has practical applications beyond laboratories and plays a crucial role in everyday life:
🍔 Food Safety Testing – Ensures food products are free from harmful bacterial contamination using CFU per mL calculation
💧 Water Quality Monitoring – Helps determine microbial load in drinking water using bacterial count calculator
🏥 Healthcare & Hospitals – Used to assess infection risks and sterilization effectiveness
🧴 Pharmaceutical Industry – Ensures drugs and cosmetics meet microbial safety standards
🌱 Agriculture & Soil Testing – Measures beneficial and harmful microbes in soil
🏠 Household Hygiene Testing – Used in research to analyze microbial presence on surfaces
⚠️ Disclaimer
⚠️ Important Disclaimer
This CFU calculator online tool is intended for educational and informational purposes only 📚. While it provides accurate results based on standard microbiology formulas, it should not replace professional laboratory analysis or certified testing procedures 🧪.
🔬 Results depend on correct input values (colonies, dilution factor, and volume plated).
📊 Always verify results with laboratory protocols and expert guidance.
🚫 Not intended for medical diagnosis or regulatory compliance decisions.
📌 Related Calculator
❓ FAQs Section
❓ What is a Colony Forming Unit (CFU)? 🧫
A Colony Forming Unit represents a viable microorganism capable of forming a colony. It is used instead of direct cell count in microbiology.
❓ How do you calculate CFU per mL? 🔬
Use the formula: CFU/mL = (Number of Colonies × Dilution Factor) ÷ Volume Plated.
❓ What is a CFU calculator used for? 📊
A CFU calculator helps determine bacterial concentration quickly and accurately, eliminating manual errors.
❓ Why is serial dilution important in CFU calculation? 🧪
Serial dilution reduces microbial concentration, allowing accurate colony counting and reliable CFU results.
❓ What is the ideal colony count range? 📈
Typically, 30–300 colonies per plate are considered statistically reliable for CFU calculations.
